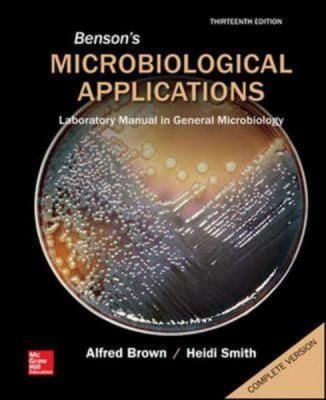
Bensons Microbiological Applications Complete Version

Author Description
null
Page Count:
0
Publication Date:
2014-01-01
ISBN-13:
9781259252167
Community Tags
Reader Comments
Share Your Thoughts
No comments yet. Be the first to share your thoughts!
null
Page Count:
0
Publication Date:
2014-01-01
ISBN-13:
9781259252167
No comments yet. Be the first to share your thoughts!